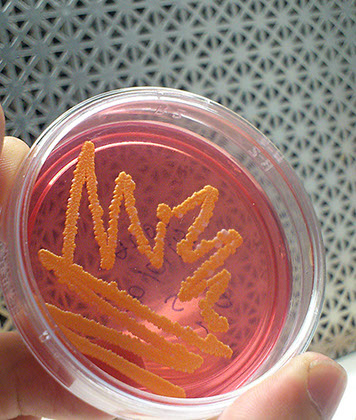

UMSNH
Programa Institucional de
Maestría en Ciencias Biológicas
Fac. de Biología | Fac. de Químico Farmacobiología
| Fac. de Med. Vet. y Zootecnia | Fac. de Agrobiología
| Instituto de Investigaciones Agropecuarias y Forestales


Listado de aspirantes de ingreso
CONVOCATORIA 2024
COORDINADORES DE ÁREAS TEMÁTICAS
Biología Evolutiva
Dr. Eduardo Cuevas García
eduardocuevas5@gmail.com
443 302 8631
Biotecnología Alimentaria
Dra. Ma. Guadalupe Garnica Romo
ggarnica@umich.mx
gromar05@yahoo.com.mx
443 314 2152, Ext.106
Biotecnología pecuaria
Dra. María Guadalupe Zavala Páramo
gzavalap@umich.mx
gzavpar@hotmail.com
443 295 8029
Ecología y conservación
Dr. Alejandro Hiram Marín Leyva
alejandro.marin@umich.mx
443 322 3500, Ext. 3033,3034
Fisiología y Genética Vegetal
Dra. Patricia Delgado Valerio
dvalerio@umich.mx
452 130 2923
Interacción planta-microorganismo- insecto
Dr. José Luciano Morales García
jose.morales@umich.mx
j.luciano58@hotmail.com
452 523 6474
Microbiologia Celular y Genética Molecular
Dr. Victor Manuel Baizabal Aguirre
baizabal@umich.mx
vmbaiza@gmail.com
443 295 8029
Producción y Salud Animal
Dr. Daniel Val Arreola
dval@umich.mx
(443) 1710229
Horarios y materias
semestre 2020-2020
Ecología y Conservación
Biotecnología Pecuaria
Acerca de
La Universidad Michoacana de San Nicolás de Hidalgo ha implementado un Programa de Maestría Institucional en el área de las Ciencias Biológicas (PIMCB), en el cual participan investigadores de cinco dependencias:
- Facultad de Químico Farmacobiología
- Facultad de Biología
- Facultad de Medicina Veterinaria y Zootecnia
- Facultad de Agrobiología
- Instituto de Investigaciones Agropecuarias y Forestales
En el PIMCB los profesores investigadores de las cinco dependencias, se agrupan en ocho áreas temáticas:
- Biología Evolutiva
- Biotecnología Alimentaria
- Biotecnología Pecuaria
- Ecología y Conservación
- Fisiología y Genética Vegetal
- Interacción Planta-Microorganismo-Insecto
- Producción y Salud Animal
- Microbiología Celular y Genética Molecular
PROGRAMA ACADÉMICO
El Programa de Maestría agrupa investigadores de las dependencias participantes en seis Áreas Temáticas con la finalidad de generar recursos humanos a nivel de Maestría con conocimientos teóricos y prácticos que les permitan participar en el desarrollo de la ciencia y tecnología en el campo de las Ciencias Biológicas y que tengan un impacto científico y tecnológico en los ámbitos regional y nacional.
El Estado de Michoacán es una zona productora de recursos naturales, agrícolas y pecuarios. La diversidad de su fauna y su flora la hace una zona rica en los recursos antes mencionados. Sin embargo, éstos no han sido aprovechados en su totalidad en forma adecuada, debido a la falta de desarrollo tecnológico y a un programa de investigación dirigido y apropiado en la región mencionada.
OBJETIVO GENERAL
Formar recursos humanos con un nivel de conocimientos y de experiencia científica en ciencias biológicas, que les permita realizar investigación original y continuar con éxito su formación académica en un programa de doctorado y/o insertarse con éxito en el sector público o privado.
OBJETIVOS PARTICULARES
Formar recursos humanos con los conocimientos y técnicas suficientes para:
- Resolver problemas de índole biológica mediante el empleo de herramientas científicas.
- Proponer y desarrollar proyectos de investigación en el área biológica.
- Generar conocimiento innovador en el área biológica.
- Continuar con éxito sus estudios de doctorado, en el área de las ciencias biológicas.
- Insertarse exitosamente en el ámbito de la producción en el sector público y en el privado así como en el académico y de investigación.
PERFIL DE INGRESO
Para ingresar al programa Institucional de Maestría en Ciencias Biológicas, el aspirante deberá poseer conocimientos académicos básicos sobre el área de las ciencias biológicas en general y medianamente avanzados sobre su proyecto de investigación en particular, así como destreza para el manejo de herramientas informáticas. Además deberá poseer conocimientos suficientes del idioma inglés para abordar la lectura y comprensión de artículos científicos sobre su tema de investigación.
PERFIL DE EGRESO
El egresado del Programa Institucional de Maestría en Ciencias Biológicas manejará con profundidad y actualización los fundamentos científicos en el área de las ciencias biológicas.
- El egresado estará capacitado en la aplicación del método científico en el área de las ciencias biológicas (identificación del problema, planteamiento de hipótesis y objetivos, estrategia metodológica, análisis de resultados y redacción de tesis).
- El egresado será capaz de participar en la propuesta y desarrollo de proyectos de investigación en el área biológica.
- El egresado tendrá la posibilidad de incorporarse a programas de Doctorado en Ciencias en el área biológica, en particular al Programa Institucional de Doctorado en Ciencias Biológicas de la U.M.S.N.H.
- El egresado será capaz de integrarse en los sectores productivos (agrícola, pesquero, acuícola, pecuario, alimentario, y ambiental), académico y de investigación.
Áreas temáticas
En el PIMCB los profesores investigadores de las 5 dependencias, se agrupan en ocho áreas temáticas:
Biotecnología Pecuaria
Interacción Planta-Microorganismo-Insecto
Fisiología y Genética Vegetal
Ecología y Conservación
Producción y Salud Animal
Microbiología Celular y Genética Molecular
Biotecnología Alimentaria
Biología Evolutiva
Núcleo académico básico
FORMATOS
Formatos de ingreso 2019
Formato de registro
Formato de carta compromiso PIMCB
Formato de carta de recomendación
Formatos de Seminario de Investigación
Seminario de Investigación I
Seminario de Investigación II
Seminario de Investigación III
Seminario de Investigación IV
Oficios
Oficio de solicitud del Comité Sinodal
Coordinación académica
Instancia académico administrativa coordinadora de las actividades académicas del PIMCB, integrado por el Coordinador General y los Coordinadores de Área Temática.
CONSEJO ACADÉMICO
Coordinador General del Programa
Dr. Luis Felipe Mendoza Cuenca
jef.div.posg.fb@umich.mx
Jefe de División de Estudios de Posgrado de la Facultad de Químico Farmacobiología
Dr. Rafael Zamora Vega
jef.div.posg.fqfb@umich.mx
Instituto de Investigaciones Agropecuarias y Forestales
Dr. Alejandro Martínez Palacios
alejmtzpalacios@gmail.com
Jefe de División de Estudios de Posgrado de la Facultad de Medicina Veterinaria y Zootecnia
Dra. Rosa Elvira Nuñez Anita
rosa.anita@umich.mx
Jefe de División de Estudios de Posgrado de la Facultad de Agrobiología "Presidente Juárez"
Dr. José Luciano Morales García
j.luciano58@hotmail.com
COORDINADORES DE ÁREAS TEMÁTICAS
Biotecnología Alimentaria
Dra. Ma. Guadalupe Garnica Romo
gromar05@yahoo.com.mx
(443) 3142152 Ext.106
Biotecnología pecuaria
Dra. María Guadalupe Zavala Páramo
gzavpar@hotmail.com
(443) 2958029
Interacción planta-microorganismo- insecto
Dr. José Luciano Morales García
j.luciano58@hotmail.com
(452) 5236474
Ecología y conservación
Dr. Alejandro Hiram Marín Leyva
alejandro.marin@umich.mx
(443) 3223500 Ext. 3033,3034
Fisiología y Genética Vegetal
Dra. Patricia Delgado Valerio
dvalerio@umich.mx
452 130 2923
Microbiologia Celular y Genética Molecular
Dr. Victor Manuel Baizabal Aguirre
vmbaiza@gmail.com
(443) 2958029
Producción y Salud Animal
Dr. Daniel Val Arreola
dval@umich.mx
(443) 1710229
Biología Evolutiva
Dr. Eduardo Cuevas García
eduardocuevas5@gmail.com
(443) 3028631
CONTACTO
División de Estudios de Posgrado de la Facultad de Biología (edifico R, Ciudad Universitaria) Francisco J. Múgica S/N, Col. Felicitas del Río
Morelia, Michoacán, México